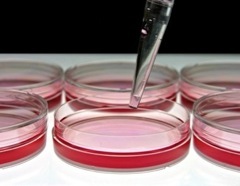

Richard Martin, Ph.D.
Director of Chemistry
Dr. Martin has 12 years of experience in the pharmaceutical industry and an excellent track record of bringing hits to leads and optimizing compounds into development candidates. He obtained his Ph.D. from the University of Toronto and pursued postdoctoral studies at the Scripps Research Institute in San Diego. Dr. Martin spent 3 years at Tanabe Research Laboratories before joining X-Ceptor therapeutics (acquired by Exelixis). He held the position of Director of Chemistry at Exelixis before joining RetroVirox. Dr. Martin has over 40 patent applications and publications in peer-reviewed journals. He has been involved in many successful programs of which 4 compounds are currently in the clinic.

© RetroVirox, Inc.